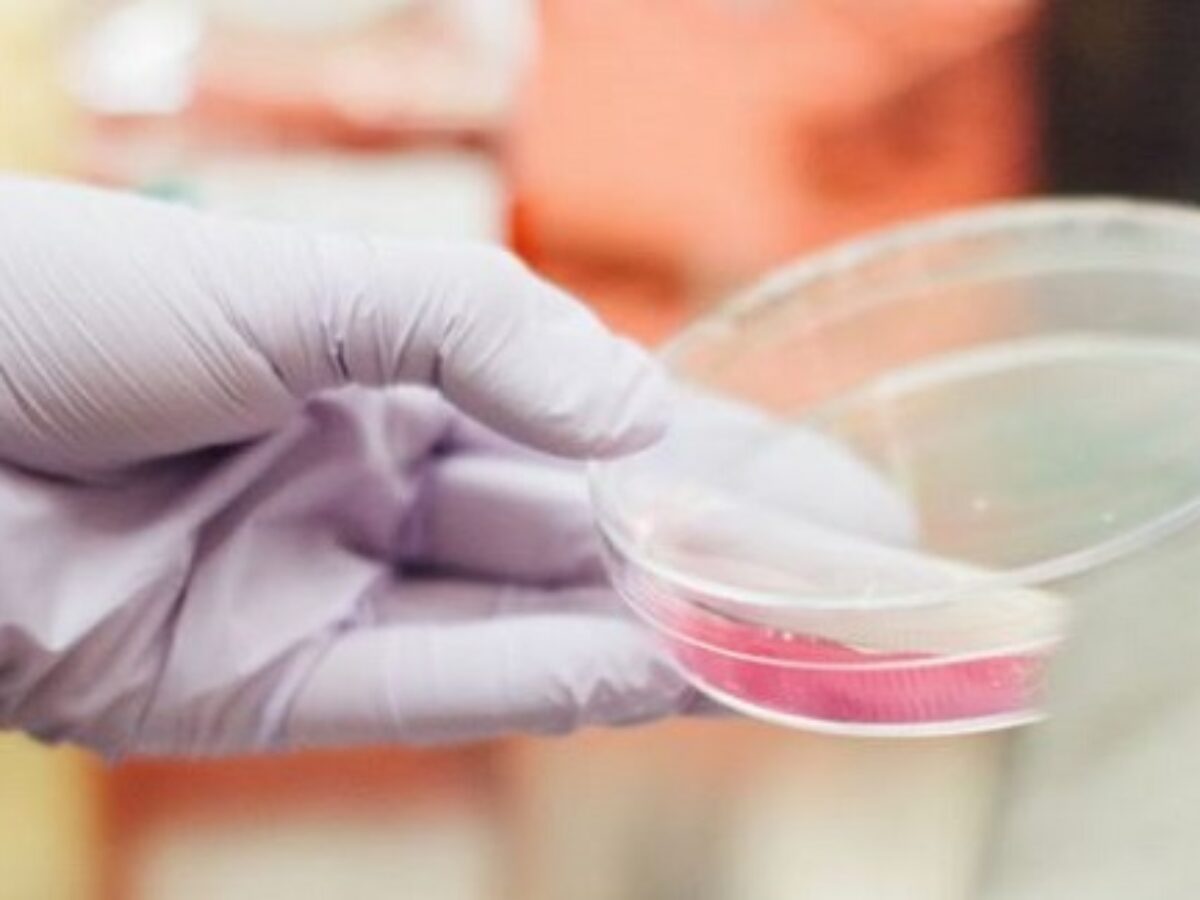

LBT Innovations and AstraZeneca to develop AI systems
Microbiology diagnostic equipment manufacturer LBT Innovations has partnered with AstraZeneca and Thermo Fisher to speed up the development of LBT's APAS AI software platform for microbial testing in the pharmaceutical sector.
The software, seen on LBT's APAS Independence laboratory instrument, speeds up the laboratory processing of clinical samples by utilising AI to scan for microbial contamination.
LBT said the partnership opened up a new market for the company with the opportunity ‘estimated at $10 billion'.
In its quarterly activities report to investors, LBT said: “The successful APAS Pharma proof of concept was an important achievement that established confidence in the APAS technology.”
Microbial quality control is a critical production control process to monitor the steps in sterile drug manufacture.
“In this process, settle plates are used continuously for the detection of microbial contamination in the air, with the vast majority, over 90 percent, of settle plates…showing no microbial growth.
“The APAS Pharma analysis modules will be developed to identify microbial growth on settle plates used in sterility monitoring during drug manufacture.
“Over $1.5 million will be received under the new collaborations.”
In December LBT received $580,000 from Thermo Fisher to develop the analysis module for Thermo Fisher's culture plate media.
In January it was engaged by AstraZeneca to validate the module for its processes. A $1 million payment is anticipated.
“Receiving funding from two global industry leaders provides a strong validation of the product-market-fit for this new application and represents a major strategic milestone for the company and the future of the APAS technology.”
Picture: LBT Innovations
Topics Technology
@aumanufacturing Sections
Analysis and Commentary Awards casino reviews Defence Gambling Manufacturing News Online Casino Podcast Technology Videos





